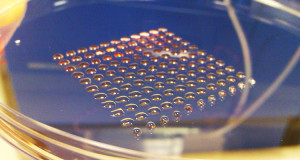
des-cellules-humaines-imprimees-en-3d-grace-a-des-micro-robots-une1

Il suffit parfois d’un esprit tordu pour transformer le message des publicitaires mais ici point besoin d’aller chercher très loin, on vous livre les vingt placements commerciaux les pires du monde !
Un Starbucks qui se transforme en “Sucks”, des publicités qui ensemble forment une suite horrible… Voilà ce que ce top 20 vous réserve :

On a adoré ces images et nous espérons qu’il en est de même pour vous ! Quelle est votre image préférée ? Si vous en connaissez d’autres, n’hésitez pas à les partager 😉